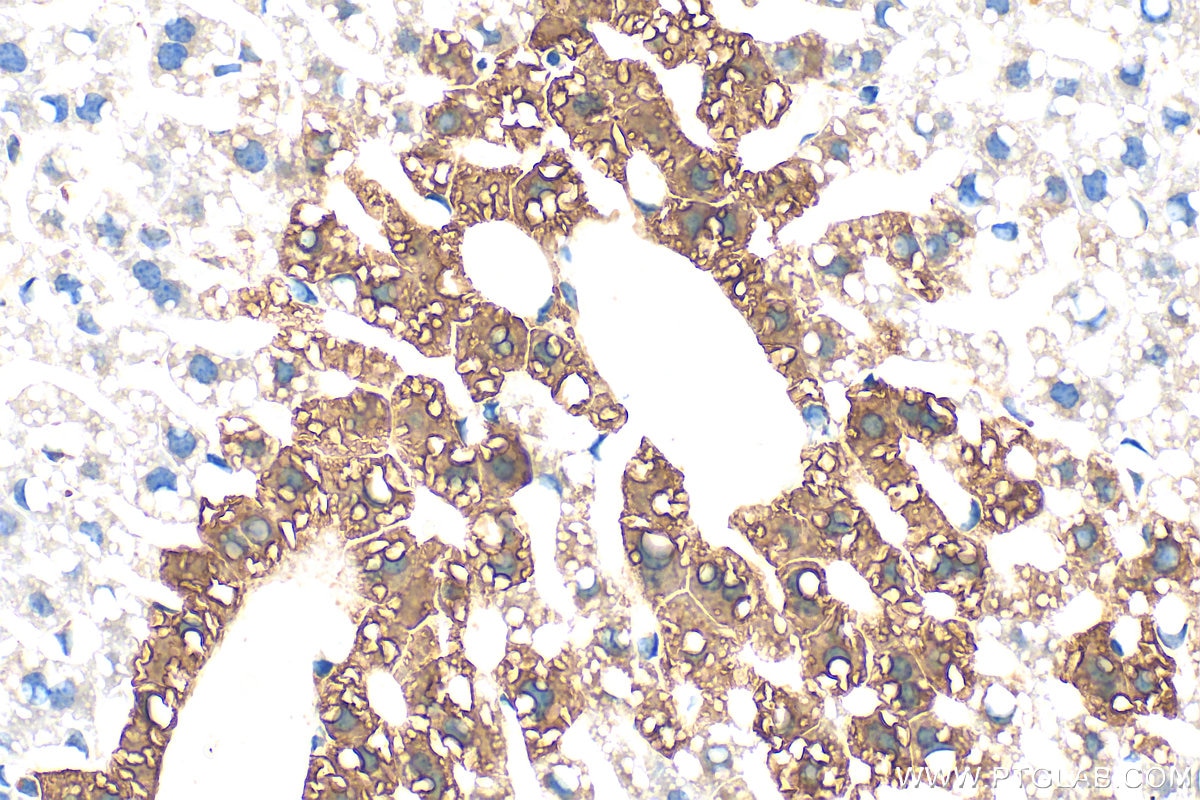
Immunohistochemistry (IHC) staining of mouse liver tissue using Glutamine Synthetase Polyclonal antibody (11037-2-AP)

Tested Applications
| Positive WB detected in | HeLa cells, Jurkat cells, mouse liver tissue, rat liver tissue |
| Positive IP detected in | mouse liver tissue |
| Positive IHC detected in | mouse liver tissue Note: suggested antigen retrieval with TE buffer pH 9.0; (*) Alternatively, antigen retrieval may be performed with citrate buffer pH 6.0 |
| Positive IF-P detected in | mouse liver tissue, human brain tissue, mouse eye tissue |
| Positive FC (Intra) detected in | Jurkat cells, HepG2 cells |
Recommended dilution
| Application | Dilution |
|---|---|
| Western Blot (WB) | WB : 1:5000-1:50000 |
| Immunoprecipitation (IP) | IP : 0.5-4.0 ug for 1.0-3.0 mg of total protein lysate |
| Immunohistochemistry (IHC) | IHC : 1:2000-1:8000 |
| Immunofluorescence (IF)-P | IF-P : 1:50-1:500 |
| Flow Cytometry (FC) (INTRA) | FC (INTRA) : 0.40 ug per 10^6 cells in a 100 µl suspension |
| It is recommended that this reagent should be titrated in each testing system to obtain optimal results. | |
| Sample-dependent, Check data in validation data gallery. | |
Published Applications
| KD/KO | See 3 publications below |
| WB | See 31 publications below |
| IHC | See 6 publications below |
| IF | See 6 publications below |
| IP | See 1 publications below |
| ELISA | See 1 publications below |
Product Information
11037-2-AP targets Glutamine Synthetase in WB, IHC, IF-P, FC (Intra), IP, ELISA applications and shows reactivity with human, mouse, rat samples.
| Tested Reactivity | human, mouse, rat |
| Cited Reactivity | human, mouse, rat |
| Host / Isotype | Rabbit / IgG |
| Class | Polyclonal |
| Type | Antibody |
| Immunogen |
CatNo: Ag1510 Product name: Recombinant human Glutamine synthetase protein Source: e coli.-derived, PGEX-4T Tag: GST Domain: 1-373 aa of BC011700 Sequence: MTTSASSHLNKGIKQVYMSLPQGEKVQAMYIWIDGTGEGLRCKTRTLDSEPKCVEELPEWNFDGSSTLQSEGSNSDMYLVPAAMFRDPFRKDPNKLVLCEVFKYNRRPAETNLRHTCKRIMDMVSNQHPWFGMEQEYTLMGTDGHPFGWPSNGFPGPQGPYYCGVGADRAYGRDIVEAHYRACLYAGVKIAGTNAEVMPAQWEFQIGPCEGISMGDHLWVARFILHRVCEDFGVIATFDPKPIPGNWNGAGCHTNFSTKAMREENGLKYIEEAIEKLSKRHQYHIRAYDPKGGLDNARRLTGFHETSNINDFSAGVANRSASIRIPRTVGQEKKGYFEDRRPSANCDPFSVTEALIRTCLLNETGDEPFQYKN Predict reactive species |
| Full Name | glutamate-ammonia ligase (glutamine synthetase) |
| Calculated Molecular Weight | 374 aa, 42 kDa |
| Observed Molecular Weight | 40-42 kDa |
| GenBank Accession Number | BC011700 |
| Gene Symbol | Glutamine Synthetase |
| Gene ID (NCBI) | 2752 |
| RRID | AB_2110650 |
| Conjugate | Unconjugated |
| Form | Liquid |
| Purification Method | Antigen affinity purification |
| UNIPROT ID | P15104 |
| Storage Buffer | PBS with 0.02% sodium azide and 50% glycerol, pH 7.3. |
| Storage Conditions | Store at -20°C. Stable for one year after shipment. Aliquoting is unnecessary for -20oC storage. 20ul sizes contain 0.1% BSA. |
Background Information
GLUL(Glutamine synthetase) is also named as GS,GLNS and belongs to the glutamine synthetase family.This enzyme has 2 functions: it catalyzes the production of glutamine and 4-aminobutanoate (gamma-aminobutyric acid, GABA), the latter in a pyridoxal phosphate-independent manner By similarity. Essential for proliferation of fetal skin fibroblasts(PMID:18662667).Defects in GLUL are the cause of congenital systemic glutamine deficiency (CSGD).Organismal glutamine production is augmented secondary to an increase in the activity of glutamine synthetase in the lung and skeletal muscle(PMID:7630137). There are other bands with higher (66 kDa, 97 kDa) and lower (30 kDa)molecular weights also detected besides the 42 kDa band indicating the proteolysis of GLUL protein by the ubiquitin system(PMID:10091759).
Protocols
| Product Specific Protocols | |
|---|---|
| FC protocol for Glutamine Synthetase antibody 11037-2-AP | Download protocol |
| IF protocol for Glutamine Synthetase antibody 11037-2-AP | Download protocol |
| IHC protocol for Glutamine Synthetase antibody 11037-2-AP | Download protocol |
| IP protocol for Glutamine Synthetase antibody 11037-2-AP | Download protocol |
| WB protocol for Glutamine Synthetase antibody 11037-2-AP | Download protocol |
| Standard Protocols | |
|---|---|
| Click here to view our Standard Protocols |
Publications
| Species | Application | Title |
|---|---|---|
Cell Metab Acetate enables metabolic fitness and cognitive performance during sleep disruption | ||
Cell Metab High dietary fructose promotes hepatocellular carcinoma progression by enhancing O-GlcNAcylation via microbiota-derived acetate
| ||
Protein Cell Follicle stimulating hormone controls granulosa cell glutamine synthesis to regulate ovulation | ||
Sci Transl Med An extracorporeal bioartificial liver embedded with 3D-layered human liver progenitor-like cells relieves acute liver failure in pigs. | ||
Cell Res Glutaminase GLS1 senses glutamine availability in a non-enzymatic manner triggering mitochondrial fusion.
|
Reviews
The reviews below have been submitted by verified Proteintech customers who received an incentive for providing their feedback.
FH Marisa (Verified Customer) (07-29-2025) | I've used this antibody for immunohistochemistry in brain slices followed by confocal microscopy, and it performed consistently well. Clear signal, minimal background, and good lot-to-lot consistency. The datasheet and customer support were also helpful. Highly recommend for confocal applications.
|
FH Andrea (Verified Customer) (09-06-2023) | antibody works perfect
|
FH Melanie (Verified Customer) (02-02-2023) | Good antibody, which works well in HEK293T cells
|
FH Ryan (Verified Customer) (02-27-2019) | Tris-HCL antigen retrieval ph=9.
![]() |